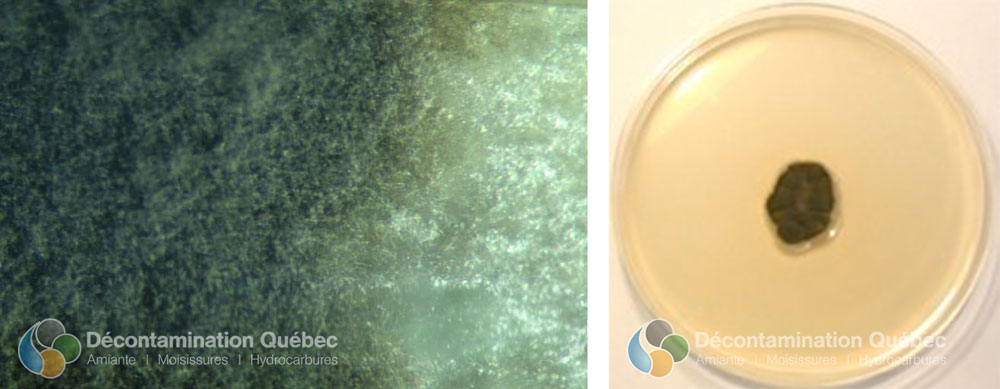
croissance de C.herbarum et Milieu M2YA

― Basé sur le Cladosporium
Par: Rodérick Bouchard
B.Sc., Microbiologiste Agréé
Dans cet article, nous explorerons plus en détails le genre de moisissure Cladosporium. Cet article est séparé en deux sections car l’Institut National de Santé Publique du Québec (INSPQ) a identifié en particulier deux espèces de Cladosporium, soit Cladosporium cladosporioides et Cladosporium herbarum.
Pour vous donner une idée générale de Cladosporium, ce sont des champignons filamenteux imparfaits appartenant à la classe des Deutéromycètes. Ce genre comprend 40 espèces environ. Ils sont cosmopolites et ubiquitaires (air, sol, plantes, céréales, produits alimentaires, etc.), extrêmement communs surtout en zone tempérée. De plus, ils sont qualifiés comme étant saprophytes et phytopathogènes . Certaines espèces provoquent des allergies de type I et III ainsi que des mycoses. Finalement, on les retrouvent dans plusieurs habitations canadiennes (100% des sites examinés dans l’étude de INSPQ), d’où l’intérêt porté à cette moisissure.
L’espèce type est Cladosporium herbarum . Effectivement, cette espèce à elle seule contient plus de 30 variétés. Elle est reconnue pour être la colonisatrice la plus rapide des substrats morts, en particulier les matières végétales. De plus, elle est reconnue comme étant un parasite chez les végétaux. Nous pouvons retrouver cette espèce un peu partout. En effet, elle peut être dans l’air, l’eau, le sol, la nourriture et dans les végétaux. Elle pousse aussi sur des matériaux de construction tels que le bois, le cuir, les matériaux synthétiques, le papier, les châssis des fenêtres et les plâtres humides. Finalement, c’est l’un des mycètes qui a une bonne résistance aux rayons UV et au rayon gamma. On peut se servir en autre de ces moisissures pour tester la résistance des matériaux aux moisissures.
Sur la photo de gauche, on voit la croissance de C.herbarum sur un parchemin, dans celle de droite c’est une croissance sur milieu M2YA. Comme vous pouvez le constater, cette espèce a des colonies qui peuvent être vertes poudreuses à olive noire. Le revers de ces colonies est noires à vert-foncé.

Cladosporium herbarum vu d’un microscope optique

Conidie de Cladosporium herbarum vu d’un microscope optique.
Le C. cladosporioides est une espèce comptant une seule variété enregistré connu. On retrouve ce mycète dans le sol, l’eau, les produits alimentaires et les produits végétales en décomposition. De plus, celle-ci se retrouve aussi dans les matériaux de construction tels que le textile, la peinture murale et la pâte à bois et sur les châssis des fenêtres. Elle est utilisée pour tester la résistance des matériaux à la moisissure. Finalement, elle peut aussi pousser sur la poussière, servant ainsi de source de nourriture aux acariens.

La photo de gauche montre une croissance de C. cladosporioides sur un parchemin tandis que celle de droite montre une croissance de celle-ci sur différents textiles. Nous observons que les colonies peuvent être marron-brun à verdâtre foncé avec des contours jaunes-orangé en vieillissant. Le revers de ces colonies est noire.
Les Cladosporium ont tous des conditions de croissance semblables, en ce qui attrait de la température, l’activité d’eau et de l’humidité. Tout d’abord, l’humidité élevé favorise la croissance. Ensuite, celle-ci peut avoir lieu à des températures entre 0°C et 35°C. La température optimale de croissance se situe entre 18°C et 28°C. Cette croissance peut aussi avoir lieu dessous du point de congélation, jusqu’à -10°C. De ce fait, les deux espèces vues ci-dessus sont aussi xérophiles et xérotolérantes, c’est-à-dire qu’elles peuvent survivre à des pressions osmotiques plus élevées que la normale où l’activité d’eau est plus faible. Cependant, des valeurs d’activité d’eau entre 0,86 et 0,88 permettront la croissance. Finalement, comme nous avons vu tantôt, Cladosporium n’est pas très difficile en matière de substrat.
Les spores de Cladosporium sont reconnues pour donner des réactions allergènes. En effet, Ils se retrouvent souvent dans les milieux intérieurs étant donné leur forte présence à l’extérieur, soit dans l’environnement. De ce fait, la présence de spores n’est pas nécessairement un problème, c’est la quantité retrouvée qui est importante. Si jamais vous voyez de la moisissure à l’œil nu, considérez cela comme un bon indicateur qu’il y a trop de moisissure dans votre domicile. Ce type de spore peut provoquer l’asthme et d’autres troubles respiratoires en grande quantité car les spores peuvent se rendre loin dans le tronc pulmonaire, jusqu’au alvéole. De plus:
Finalement, même si la plupart des Cladosporium ne sont pas pathogènes en eux-mêmes, certaines espèces le sont et ils peuvent être responsable d’infections dîtes opportunistes.
Tout d’abord, il y a l’inspection visuelle des lieux. Regarder si vous voyez des taches semblables à celle montrée sur les photos ci-dessus dans une pièce de la maison, sur la nourriture ou sur les plantes. Ensuite, servez-vous de votre odorat. Si vous avez une pièce avec une odeur de moisi, de terre ou de renfermé, il se peut qu’il y ait présence de Cladosporium dans votre domicile ou d’autre moisissure. Finalement, si vous constatez que vous ou des occupants de votre domicile présentent des symptômes chroniques semblables à ceux nommé ci-dessus.
Ces trucs sont semblables dans tous les articles car ce sont des trucs pour identifier des moisissures. Vous ne pourrez pas confirmer à quel type de moisissure vous avez à faire sans analyse microscopique car certaines moisissures sont très semblables macroscopiquement. Exemple: Un endroit contaminé par des traces noire pourrait indiquer autant la présence de Penicillium, d’Aspergillus ou de Stachybotrys. Retenez que si la moisissure est visible, c’est signe qu’il y en a trop et que vous devriez l’enlevez immédiatement.
Nous espérons que cet article vous en a un peu plus appris sur Cladosporium. Si vous avez des doutes que votre habitation contient de la moisissure ou pour tout autre question concernant ce sujet, nous pourrons faire une évaluation à savoir s’il y a bien présence de Cladosporium ou d’autres genres de moisissures avec les tests appropriés à votre domicile. Notre équipe de professionnel sait comment confirmer la présence de moisissure et éliminer celle-ci sans risque pour votre santé.
Vous pouvez nous joindre par téléphone au (418) 476-0360 ou par courriel à infos@decontaminationquebec.com. Il nous fera plaisir de vous aider.
―